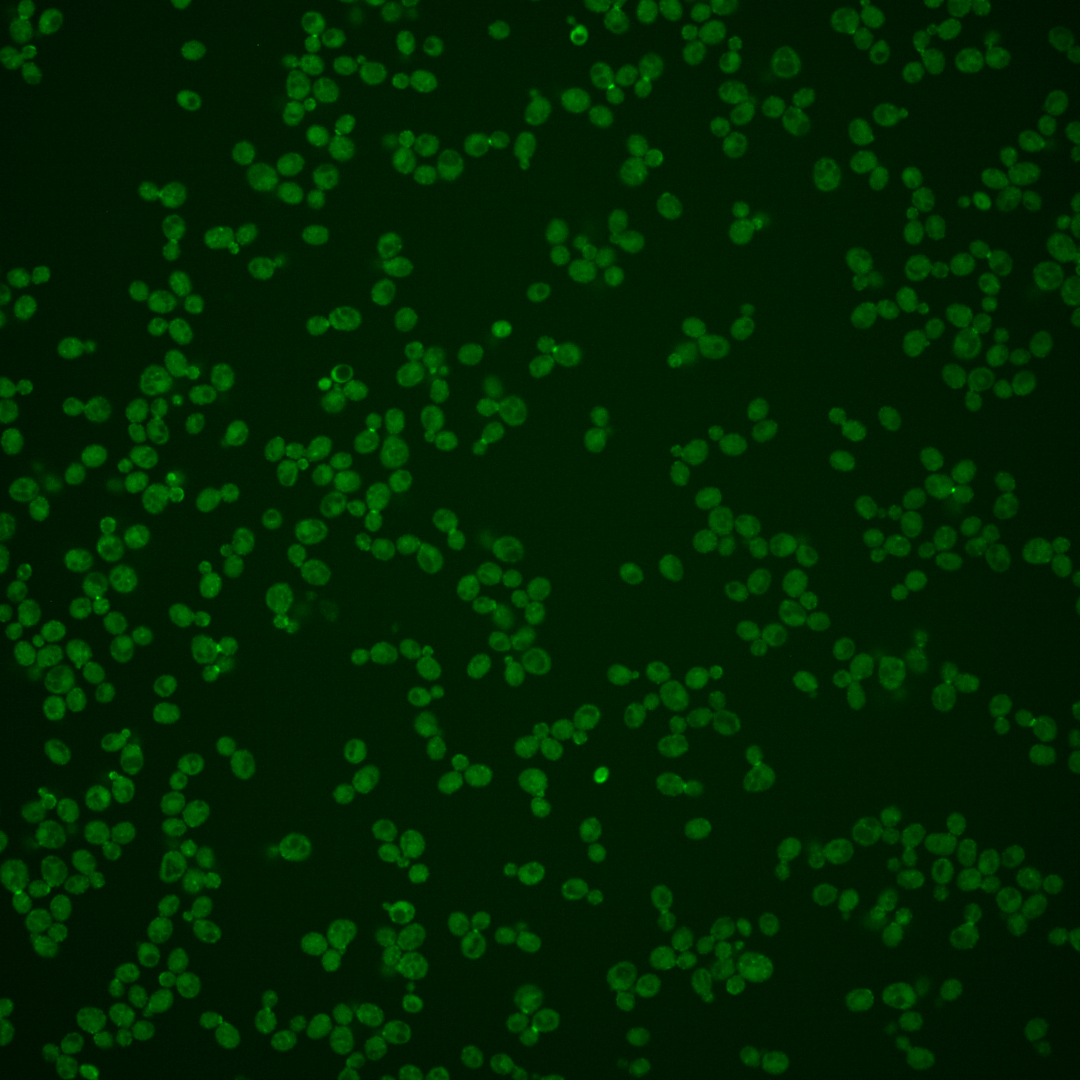
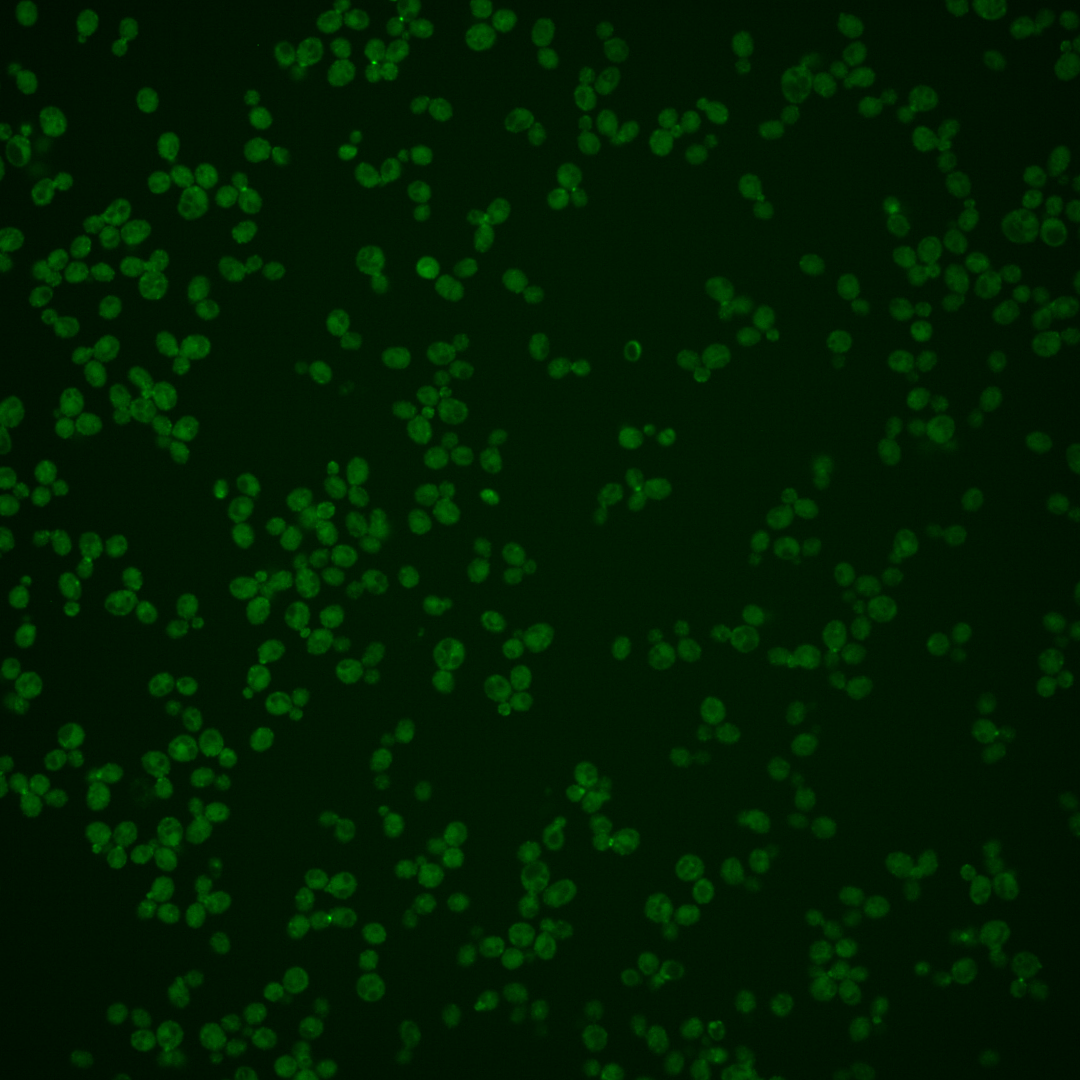

| Standard name | |
|---|---|
| Human Ortholog | |
| Description | Transmembrane osmosensor for filamentous growth and HOG pathways; involved in activation of the Cdc42p- and MAP kinase-dependent filamentous growth pathway and the high-osmolarity glycerol (HOG) response pathway; phosphorylated by Hog1p; interacts with Pbs2p, Msb2p, Hkr1p, and Ste11p |
Micrographs




















































































Sub-cellular Localization
Yeast GFP Assignment
Protein Abundance
Localization Change
External localization resources
| ensLOC | DeepLoc | |||||||||||||||||||||||
|---|---|---|---|---|---|---|---|---|---|---|---|---|---|---|---|---|---|---|---|---|---|---|---|---|
| Localization | WT1 | WT2 | WT3 | RAP60 | RAP140 | RAP220 | RAP300 | RAP380 | RAP460 | RAP540 | RAP620 | RAP700 | HU80 | HU120 | HU160 | rpd3Δ_1 | rpd3Δ_2 | rpd3Δ_3 | WT1 | WT2 | WT3 | AF100 | AF140 | AF180 |
| Cortical Patches | 54 | 30 | 74 | 64 | 52 | 68 | 30 | 11 | – | 19 | 17 | 14 | 30 | 38 | 22 | 4 | 12 | 7 | 47 | 25 | 104 | 21 | 47 | 35 |
| Bud | 10 | 8 | 47 | 32 | 53 | 75 | 87 | 74 | – | 62 | 61 | 65 | 14 | 14 | 2 | 0 | 3 | 0 | 17 | 20 | 14 | 22 | 53 | 35 |
| Bud Neck | 0 | 0 | 0 | 1 | 2 | 1 | 3 | 0 | – | 3 | 1 | 1 | 0 | 0 | 0 | 0 | 0 | 0 | 28 | 21 | 22 | 18 | 31 | 22 |
| Bud Site | 7 | 6 | 9 | 11 | 7 | 14 | 10 | 5 | – | 1 | 4 | 3 | 1 | 1 | 0 | 0 | 0 | 0 | – | – | – | – | – | – |
| Cell Periphery | 4 | 1 | 3 | 3 | 2 | 1 | 7 | 8 | – | 11 | 7 | 5 | 6 | 12 | 8 | 0 | 0 | 1 | 1 | 0 | 4 | 0 | 0 | 0 |
| Cytoplasm | 83 | 72 | 133 | 202 | 320 | 452 | 586 | 617 | – | 595 | 452 | 551 | 60 | 72 | 101 | 32 | 34 | 21 | 6 | 10 | 7 | 3 | 5 | 5 |
| Endoplasmic Reticulum | 57 | 37 | 70 | 45 | 29 | 51 | 28 | 19 | – | 20 | 5 | 12 | 36 | 41 | 44 | 3 | 2 | 2 | 84 | 43 | 93 | 8 | 20 | 28 |
| Endosome | 14 | 2 | 17 | 6 | 49 | 28 | 39 | 24 | – | 35 | 5 | 8 | 1 | 7 | 11 | 4 | 5 | 1 | 18 | 6 | 40 | 7 | 14 | 14 |
| Golgi | 0 | 0 | 0 | 1 | 0 | 0 | 0 | 0 | – | 0 | 0 | 0 | 0 | 1 | 1 | 2 | 0 | 3 | 10 | 1 | 13 | 1 | 1 | 4 |
| Mitochondria | 1 | 2 | 26 | 11 | 13 | 62 | 124 | 121 | – | 107 | 133 | 163 | 1 | 0 | 0 | 5 | 6 | 2 | 4 | 3 | 24 | 8 | 14 | 8 |
| Nucleus | 1 | 0 | 0 | 2 | 3 | 3 | 4 | 10 | – | 5 | 2 | 3 | 0 | 0 | 0 | 0 | 0 | 0 | 0 | 0 | 0 | 0 | 2 | 1 |
| Nuclear Periphery | 0 | 0 | 1 | 2 | 1 | 5 | 2 | 4 | – | 4 | 0 | 0 | 0 | 0 | 0 | 0 | 0 | 0 | 0 | 0 | 1 | 0 | 1 | 1 |
| Nucleolus | 0 | 1 | 1 | 0 | 1 | 0 | 3 | 10 | – | 3 | 0 | 1 | 0 | 0 | 0 | 0 | 0 | 0 | 0 | 0 | 0 | 0 | 0 | 0 |
| Peroxisomes | 18 | 10 | 11 | 24 | 23 | 9 | 14 | 4 | – | 3 | 3 | 2 | 1 | 2 | 0 | 0 | 1 | 0 | 1 | 0 | 3 | 3 | 2 | 1 |
| SpindlePole | 3 | 2 | 7 | 8 | 13 | 13 | 19 | 13 | – | 10 | 2 | 9 | 1 | 2 | 1 | 0 | 1 | 0 | 2 | 2 | 0 | 0 | 0 | 1 |
| Vac/Vac Membrane | 44 | 5 | 11 | 8 | 32 | 30 | 40 | 42 | – | 61 | 23 | 37 | 2 | 4 | 12 | 32 | 33 | 22 | 88 | 42 | 70 | 25 | 60 | 64 |
| Unique Cell Count | 240 | 139 | 318 | 342 | 492 | 667 | 835 | 836 | 800 | 583 | 733 | 131 | 154 | 172 | 73 | 81 | 55 | 315 | 181 | 407 | 125 | 258 | 232 | |
| Labelled Cell Count | 296 | 176 | 410 | 420 | 600 | 812 | 996 | 962 | 939 | 715 | 874 | 153 | 194 | 202 | 82 | 97 | 59 | 315 | 181 | 407 | 125 | 258 | 232 | |
Yeast GFP Assignment
Protein Abundance
| Screen | WT1 | WT2 | WT3 | RAP60 | RAP140 | RAP220 | RAP300 | RAP380 | RAP460 | RAP540 | RAP620 | RAP700 | HU80 | HU120 | HU160 | rpd3Δ_1 | rpd3Δ_2 | rpd3Δ_3 | AF100 | AF140 | AF180 |
|---|---|---|---|---|---|---|---|---|---|---|---|---|---|---|---|---|---|---|---|---|---|
| Mean Cell GFP Intensity (1e-4) | 8.2 | 8.6 | 6.0 | 6.0 | 5.8 | 5.5 | 4.6 | 4.9 | – | 4.5 | 4.3 | 4.3 | 7.6 | 8.1 | 8.5 | 10.9 | 10.2 | 10.7 | 8.7 | 9.0 | 8.8 |
| Std Deviation (1e-4) | 1.1 | 1.5 | 1.0 | 1.4 | 1.2 | 1.5 | 1.1 | 1.2 | – | 1.3 | 0.9 | 0.9 | 1.1 | 1.4 | 1.7 | 2.4 | 2.4 | 2.4 | 1.4 | 1.7 | 2.1 |
| Intensity Change (Log2) | – | – | – | 0.01 | -0.03 | -0.11 | -0.38 | -0.3 | – | -0.39 | -0.47 | -0.48 | 0.34 | 0.44 | 0.51 | 0.86 | 0.78 | 0.84 | 0.55 | 0.59 | 0.56 |
Localization Change
| Localization | RAP60 | RAP140 | RAP220 | RAP300 | RAP380 | RAP460 | RAP540 | RAP620 | RAP700 | HU80 | HU120 | HU160 | rpd3Δ_1 | rpd3Δ_2 | rpd3Δ_3 |
|---|---|---|---|---|---|---|---|---|---|---|---|---|---|---|---|
| Cortical Patches | -1.4 | -4.9 | -5.5 | 0 | 0 | – | 0 | 0 | 0 | -0.1 | 0.3 | -2.8 | -3.4 | -1.7 | -1.8 |
| Bud | -2.1 | -1.7 | -1.6 | 0 | 0 | – | 0 | 0 | 0 | -1.2 | -1.7 | -4.8 | -3.5 | -2.7 | -3.0 |
| Bud Neck | 0 | 0 | 0 | 0 | 0 | – | 0 | 0 | 0 | 0 | 0 | 0 | 0 | 0 | 0 |
| Bud Site | 0.3 | -1.4 | -0.7 | 0 | 0 | – | 0 | 0 | 0 | 0 | 0 | 0 | 0 | 0 | 0 |
| Cell Periphery | 0 | 0 | 0 | 0 | 0 | – | 0 | 0 | 0 | 0 | 0 | 0 | 0 | 0 | 0 |
| Cytoplasm | 4.4 | 6.5 | 7.8 | 8.9 | 10.2 | – | 10.3 | 10.7 | 10.4 | 0.8 | 1.0 | 3.6 | 0.3 | 0 | -0.5 |
| Endoplasmic Reticulum | -3.0 | -6.8 | -6.4 | 0 | 0 | – | 0 | 0 | 0 | 1.2 | 1.1 | 0.9 | -3.5 | -4.1 | -3.2 |
| Endosome | -2.5 | 2.3 | -0.8 | 0 | 0 | – | 0 | 0 | 0 | -2.3 | -0.4 | 0.5 | 0 | 0 | 0 |
| Golgi | 0 | 0 | 0 | 0 | 0 | – | 0 | 0 | 0 | 0 | 0 | 0 | 0 | 0 | 0 |
| Mitochondria | -2.8 | -3.6 | 0.6 | 0 | 0 | – | 0 | 0 | 0 | -3.0 | -3.7 | -3.9 | -0.4 | -0.2 | 0 |
| Nucleus | 0 | 0 | 0 | 0 | 0 | – | 0 | 0 | 0 | 0 | 0 | 0 | 0 | 0 | 0 |
| Nuclear Periphery | 0 | 0 | 0 | 0 | 0 | – | 0 | 0 | 0 | 0 | 0 | 0 | 0 | 0 | 0 |
| Nucleolus | 0 | 0 | 0 | 0 | 0 | – | 0 | 0 | 0 | 0 | 0 | 0 | 0 | 0 | 0 |
| Peroxisomes | 2.0 | 0.8 | -2.2 | 0 | 0 | – | 0 | 0 | 0 | 0 | 0 | 0 | 0 | 0 | 0 |
| SpindlePole | 0.1 | 0.4 | -0.3 | 0 | 0 | – | 0 | 0 | 0 | 0 | 0 | 0 | 0 | 0 | 0 |
| Vacuole | -0.9 | 1.9 | 0.8 | 1.0 | 1.1 | – | 2.6 | 0.4 | 1.1 | 0 | 0 | 1.8 | 9.9 | 9.6 | 0 |
External localization resources
Images






























Protein Concentration and Protein Localization Data
| R1 | R2 | R3 | ||||||||||||||||
|---|---|---|---|---|---|---|---|---|---|---|---|---|---|---|---|---|---|---|
| G1 Pre-START | G1 Post-START | S/G2 | Metaphase | Anaphase | Telophase | G1 Pre-START | G1 Post-START | S/G2 | Metaphase | Anaphase | Telophase | G1 Pre-START | G1 Post-START | S/G2 | Metaphase | Anaphase | Telophase | |
| Concentration | 3.0525 | 4.2213 | 4.1998 | 3.6234 | 3.4248 | 3.9813 | 4.8054 | 6.4902 | 6.1237 | 5.6107 | 6.0095 | 5.9961 | 2.7454 | 4.0586 | 3.8538 | 3.2662 | 3.3877 | 3.786 |
| Actin | 0.072 | 0.0424 | 0.0692 | 0.0571 | 0.0694 | 0.0313 | 0.0813 | 0.0221 | 0.0714 | 0.0356 | 0.0302 | 0.0639 | 0.0542 | 0.0229 | 0.0518 | 0.0396 | 0.0088 | 0.0193 |
| Bud | 0.0269 | 0.0265 | 0.1371 | 0.0522 | 0.0291 | 0.0086 | 0.0203 | 0.0188 | 0.0687 | 0.0105 | 0.0036 | 0.0037 | 0.0303 | 0.0165 | 0.1022 | 0.0216 | 0.0185 | 0.0025 |
| Bud Neck | 0.0396 | 0.0088 | 0.0075 | 0.0117 | 0.0103 | 0.514 | 0.0332 | 0.0165 | 0.0097 | 0.003 | 0.007 | 0.5015 | 0.0315 | 0.0138 | 0.0069 | 0.0093 | 0.0343 | 0.5666 |
| Bud Periphery | 0.057 | 0.0487 | 0.3031 | 0.1738 | 0.076 | 0.0186 | 0.0609 | 0.0346 | 0.205 | 0.1057 | 0.0128 | 0.008 | 0.0771 | 0.021 | 0.204 | 0.1 | 0.0486 | 0.0061 |
| Bud Site | 0.1616 | 0.2373 | 0.0665 | 0.0273 | 0.0375 | 0.0083 | 0.1246 | 0.2839 | 0.0563 | 0.0026 | 0.0078 | 0.0073 | 0.1017 | 0.2627 | 0.0593 | 0.0115 | 0.0042 | 0.0067 |
| Cell Periphery | 0.013 | 0.0045 | 0.0049 | 0.0051 | 0.0115 | 0.0053 | 0.0363 | 0.0087 | 0.0073 | 0.0076 | 0.013 | 0.0054 | 0.0187 | 0.003 | 0.0048 | 0.0047 | 0.0034 | 0.0045 |
| Cytoplasm | 0.1658 | 0.2754 | 0.1279 | 0.1329 | 0.2074 | 0.1303 | 0.2165 | 0.156 | 0.1351 | 0.2668 | 0.222 | 0.1094 | 0.1888 | 0.149 | 0.1039 | 0.1326 | 0.1828 | 0.0834 |
| Cytoplasmic Foci | 0.0797 | 0.0525 | 0.0367 | 0.0408 | 0.0894 | 0.0583 | 0.0704 | 0.0647 | 0.0473 | 0.0481 | 0.0826 | 0.044 | 0.07 | 0.0572 | 0.0404 | 0.0373 | 0.0778 | 0.0457 |
| Eisosomes | 0.0006 | 0.0001 | 0.0002 | 0.0002 | 0.0006 | 0.0002 | 0.0012 | 0.0002 | 0.0012 | 0.0001 | 0.0002 | 0.0003 | 0.0005 | 0.0001 | 0.0004 | 0.0003 | 0.0001 | 0.0001 |
| Endoplasmic Reticulum | 0.0155 | 0.0188 | 0.0064 | 0.0126 | 0.0106 | 0.0114 | 0.026 | 0.0292 | 0.0156 | 0.014 | 0.0203 | 0.0138 | 0.0218 | 0.0142 | 0.0111 | 0.026 | 0.0191 | 0.0096 |
| Endosome | 0.1517 | 0.1487 | 0.1125 | 0.2486 | 0.2046 | 0.1039 | 0.1356 | 0.1886 | 0.1837 | 0.2443 | 0.3457 | 0.1221 | 0.1933 | 0.2633 | 0.2228 | 0.3484 | 0.3297 | 0.1298 |
| Golgi | 0.0591 | 0.0389 | 0.0434 | 0.0744 | 0.0925 | 0.0428 | 0.0504 | 0.0518 | 0.069 | 0.1681 | 0.1178 | 0.0445 | 0.0544 | 0.0466 | 0.057 | 0.0572 | 0.0978 | 0.052 |
| Lipid Particles | 0.0329 | 0.0112 | 0.0055 | 0.0077 | 0.0111 | 0.0125 | 0.0345 | 0.0169 | 0.0096 | 0.0068 | 0.0225 | 0.0087 | 0.0202 | 0.006 | 0.0049 | 0.0286 | 0.0172 | 0.0059 |
| Mitochondria | 0.0272 | 0.0071 | 0.0127 | 0.0396 | 0.0311 | 0.0163 | 0.0112 | 0.0066 | 0.0228 | 0.0056 | 0.0086 | 0.0064 | 0.0092 | 0.0106 | 0.0172 | 0.0121 | 0.011 | 0.0069 |
| None | 0.008 | 0.0123 | 0.0066 | 0.0031 | 0.0121 | 0.003 | 0.0158 | 0.0162 | 0.0034 | 0.002 | 0.0022 | 0.012 | 0.0078 | 0.0047 | 0.0058 | 0.0058 | 0.0045 | 0.007 |
| Nuclear Periphery | 0.0092 | 0.0029 | 0.0022 | 0.0029 | 0.003 | 0.0007 | 0.0036 | 0.003 | 0.0042 | 0.0019 | 0.0021 | 0.0006 | 0.0037 | 0.0026 | 0.0027 | 0.0052 | 0.0093 | 0.0013 |
| Nucleolus | 0.0014 | 0.0008 | 0.0011 | 0.0006 | 0.006 | 0.0005 | 0.0013 | 0.0025 | 0.0008 | 0.0003 | 0.0002 | 0.0008 | 0.0014 | 0.0012 | 0.0011 | 0.0004 | 0.0005 | 0.0005 |
| Nucleus | 0.0039 | 0.0029 | 0.0032 | 0.0025 | 0.0219 | 0.0016 | 0.0022 | 0.0121 | 0.0019 | 0.001 | 0.0012 | 0.0011 | 0.0025 | 0.0027 | 0.0026 | 0.0018 | 0.0022 | 0.0013 |
| Peroxisomes | 0.0144 | 0.0021 | 0.0057 | 0.0018 | 0.0071 | 0.0047 | 0.0093 | 0.0018 | 0.0119 | 0.0011 | 0.0037 | 0.0027 | 0.0032 | 0.002 | 0.0022 | 0.0095 | 0.0077 | 0.0032 |
| Punctate Nuclear | 0.0034 | 0.0016 | 0.002 | 0.0005 | 0.004 | 0.0024 | 0.0044 | 0.0047 | 0.001 | 0.0003 | 0.0004 | 0.0004 | 0.0024 | 0.0012 | 0.0008 | 0.0019 | 0.0023 | 0.0017 |
| Vacuole | 0.0509 | 0.0511 | 0.0384 | 0.088 | 0.0592 | 0.0219 | 0.0559 | 0.0564 | 0.0617 | 0.0664 | 0.0875 | 0.0383 | 0.1006 | 0.0895 | 0.082 | 0.1272 | 0.1044 | 0.0403 |
| Vacuole Periphery | 0.0062 | 0.0052 | 0.0072 | 0.0164 | 0.0055 | 0.0034 | 0.0052 | 0.0048 | 0.0121 | 0.0082 | 0.0085 | 0.005 | 0.0067 | 0.009 | 0.0161 | 0.0189 | 0.0156 | 0.0054 |
Sequencing Data
| R1 | R2 | |||||||||
|---|---|---|---|---|---|---|---|---|---|---|
| G1 Post-START | S/G2 | Metaphase | Anaphase | Telophase | G1 Post-START | S/G2 | Metaphase | Anaphase | Telophase | |
| Gene Expression | 50.4728 | 33.0579 | 18.5635 | 28.3296 | 41.467 | 28.9683 | 22.8102 | 24.3886 | 19.8917 | 48.1946 |
| Translational Efficiency | 1.4383 | 1.1306 | 1.3043 | 0.852 | 1.1742 | 2.1978 | 1.5949 | 0.8982 | 1.0371 | 1.0158 |
Hit Data
| Dataset | Hit |
|---|---|
| Protein Concentration | ✔ |
| Protein Localization | ✔ |
| Gene Expression | ✔ |
| Translational Efficiency | ✘ |
Endocytosis
| Temp | Actin Patch (Sac6-tdTomato) | Cortical Patch (Sla1-GFP) | Late Endosome (Snf7-GFP) | Vacuole (Vph1-GFP) |
|---|---|---|---|---|
| 37℃ | ||||
| RT |
Cell Cycle Omics
CYCLoPs (Sho1-GFP)
| Gene / Allele | Actin Patch (Sac6-tdTomato) | Cortical Patch (Sla1-GFP) | Late Endosome (Snf7-GFP) | Vacuole (Sac6-tdTomato) |
|---|
| Gene | Images |
|---|
| Gene | Images |
|---|
Images are not yet available
Images are not yet available